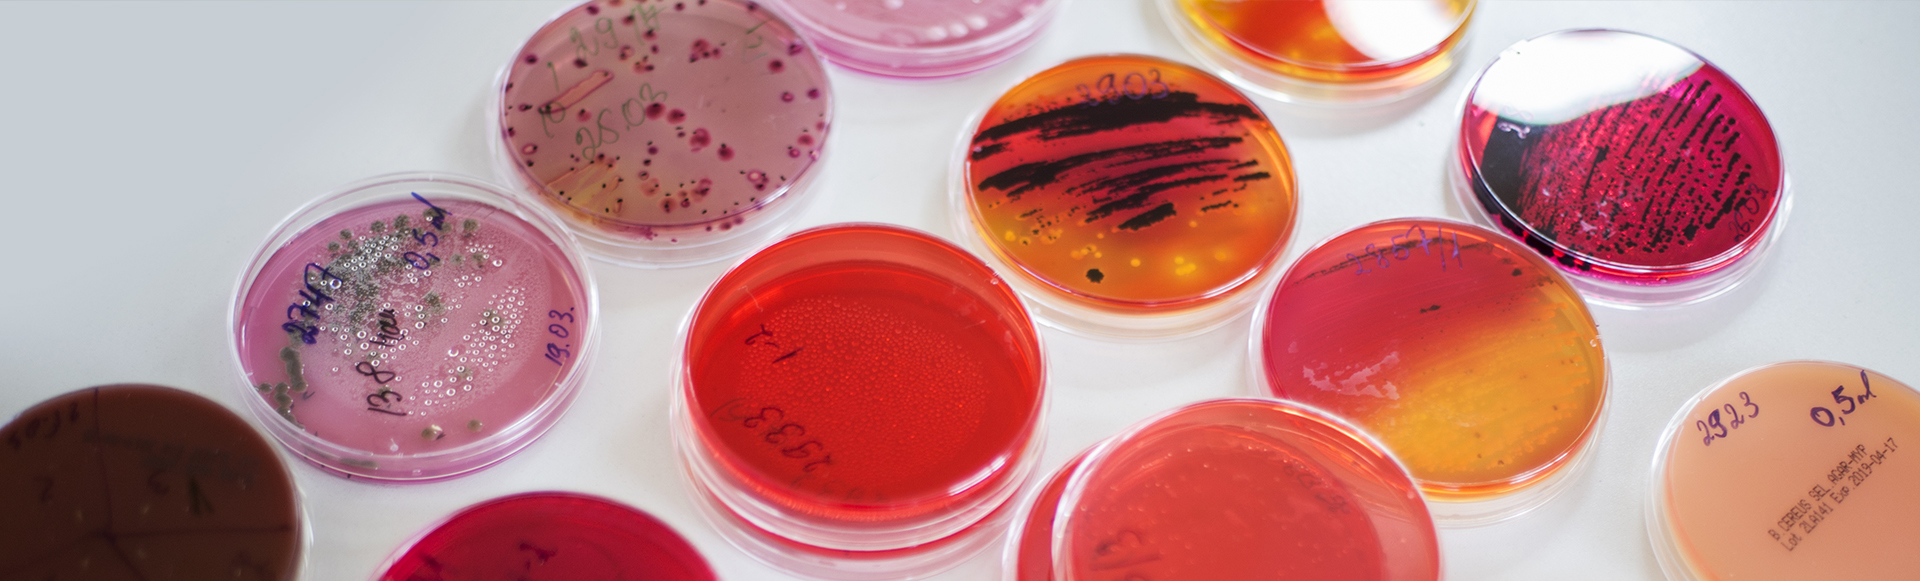
Slide1 background
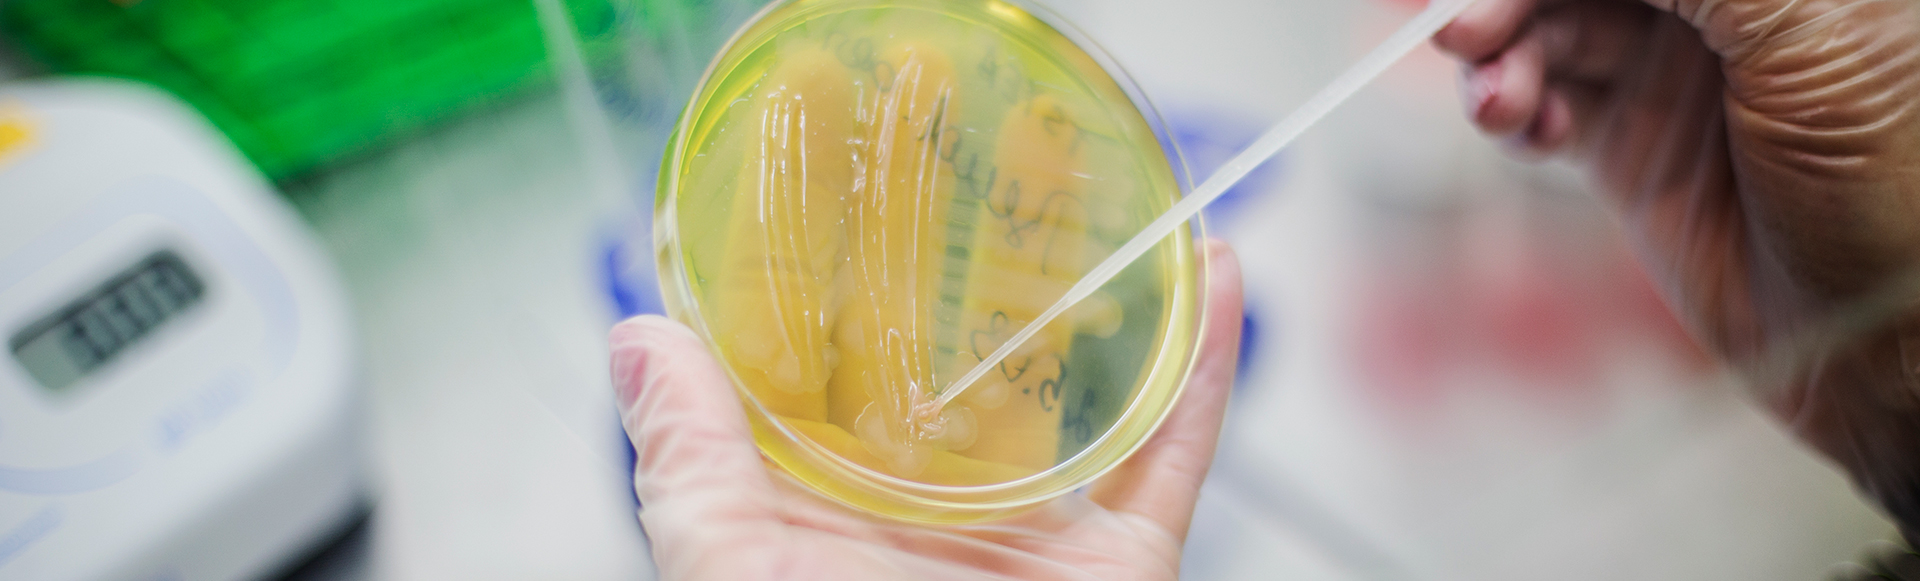
Slide1 background

Ko piedāvā Auctoritas? Šie ir standarta pakalpojumi. Lai precizētu pakalpojumu klāstu, lūdzu sazinies ar mums
-
Ūdens analīzes
Ūdens fizikāli – ķīmiskā testēšana (kārtējais monitorings), E.coli, koliformas, Zarnu enterokoki, u.c.
-
Partikas un dzīvnieku barības analīzes
Mikroorganismu skaits (MAFAM), Koliformas (ZNGB), Koliformu skaits, Escherichia coli skaits, u.c.
-
Mikrobioloģiskās analīzes kautuvēm
Depslides (kontaktplašu metode mikroorganismu skaita un enterobaktēriju noteikšanai), Salmonellas, u.c.
-
Mēslošanas līdzekļu analīzes
Enterokoki, Escherichia coli skaits, Salmonellas.
-
Virsmu nomazgājumu analīzes
Koliformas, Staphylococcus aureus, Listeria monocytogenes (klātbūtne), Enterobacteriaceae skaits, Pelējumi, u.c.
-
Kosmētikas mikrobioloģiskās analīzes
Mikroorganismu skaits, Staphylococcus aureus, Pseudomonas aeruginosa, Candida albicans, Escherichia coli, u.c.
-
Gaisa analīzes
Mikroorganismu skaita noteikšana Sedimentācijas metode, Pelējumu skaita noteikšana Sedimentācijas metode.
-
Derīguma termiņa apstiprināšana
Atbilstošos apstākļos, t.sk. noteiktā temperatūrā, uzglabājam produktu paraugus līdz testēšanas plāna izpildes beigām